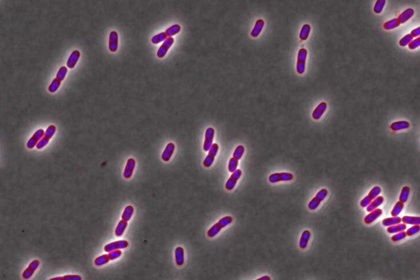
Названа опасность популярных бытовых товаров

Названа опасность популярных бытовых товаров
Названа опасность популярных бытовых товаров
Ученые Вашингтонского университета в Сент-Луисе выяснили, что триклозан — компонент антибактериальных средств и других бытовых товаров — делает микробы невосприимчивыми к действию антибиотиков. При этом бактерии могут пережить даже смертельные концентрации лекарственных препаратов, включая те, что используются при инфекции мочевыводящих путей. Об этом сообщается в пресс-релизе на Phys.org.
В новой работе исследователи продемонстрировали, как воздействие триклозана влияет на способность организма мышей реагировать на антибиотики при инфекции. Одна группа грызунов подвергалась воздействию триклозана до введения бактерицидного препарата ципрофлоксацина, а другая группа лечилась только антибиотиками. Ципрофлоксацин является наиболее часто применяемым средством при бактериальном поражении мочевыводящих путей.
Результаты измерения содержания триклозана в моче грызунов показали, что его уровень схож с тем, что наблюдается у людей. При этом дезинфицирующее вещество увеличивало количество клеток бактерий в мочевом пузыре, выживших при дальнейшем лечении. В норме должен оставаться один из миллиона микроорганизмов, однако в данном случае один из десяти микробов выдерживал действие ципрофлоксацина.
Ученые выяснили, что триклозан влияет на активность молекулы ppGpp, являющейся ингибитором роста клетки. Во время стресса ppGpp останавливает биосинтез клеточных компонентов (ДНК, РНК, белки), перенаправляя ресурсы на обеспечение выживания. Поэтому препараты, замедляющие рост бактерий, нельзя принимать до антибиотиков, которые могут стать неэффективными. Показано, что отсутствие ppGpp лишает триклозан способности вызывать устойчивость к лечению.
Триклозан содержится во множество потребительских товаров. Его добавляют в зубную пасту, жидкость для полоскания рта, косметику, одежду, детские игрушки и кредитные карты с целью предотвращения роста бактерий.
https://lenta.ru
